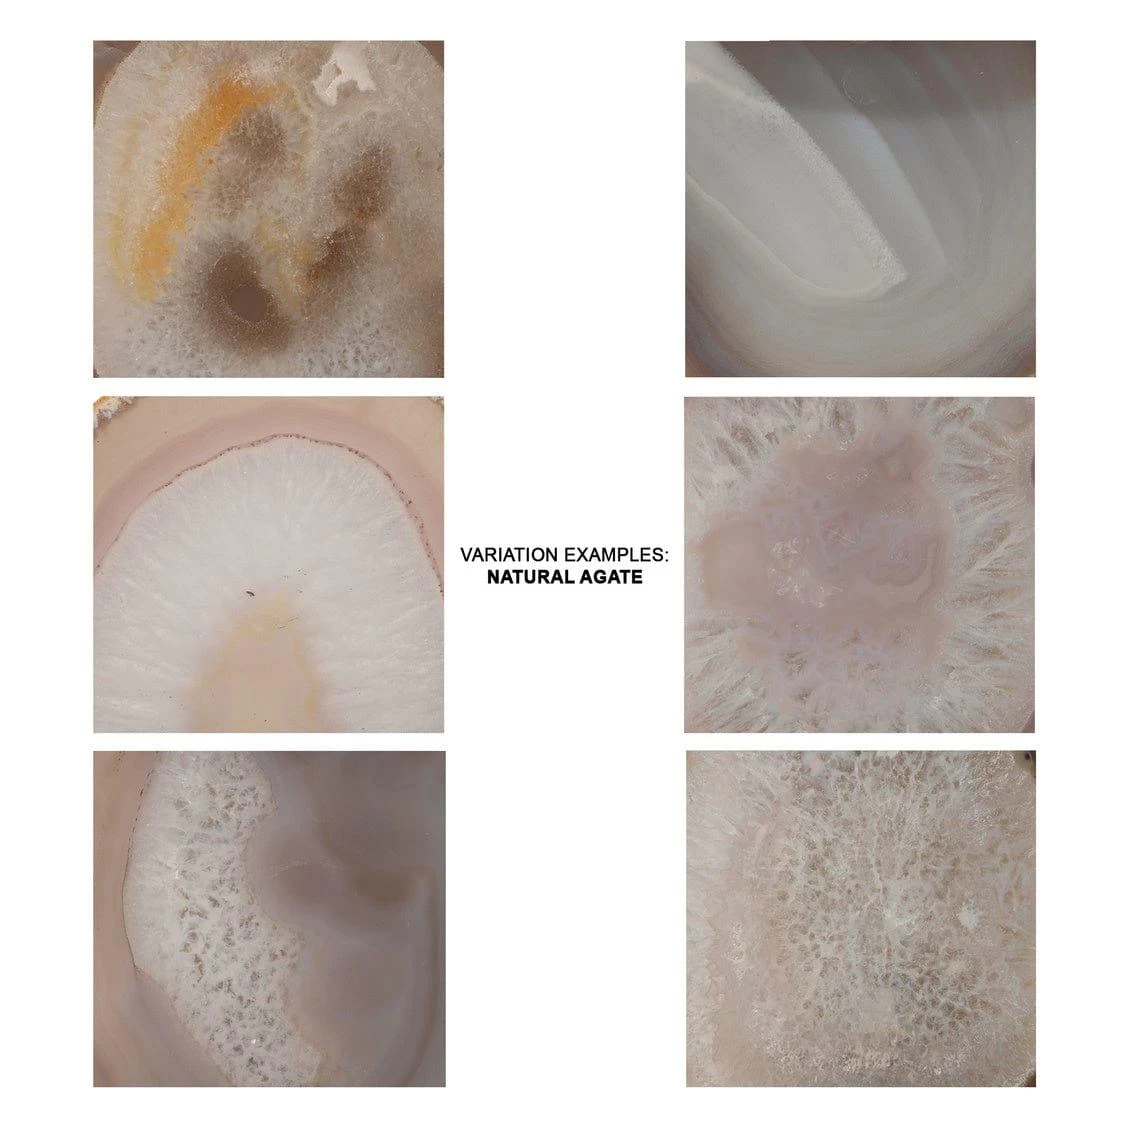
Reversible Purple Agate Stone Trinity Wall Sconce - Large 8 Reversible Purple Agate Stone Trinity Wall Sconce - Large - Image 8

Reversible Position Purple Agate Stone Trinity Wall Sconce – Large
Five unique slices of Natural agate stone are individually arranged to create extraordinary pieces of art. Embrace this wall sconce’s individuality and you will have a truly one-of-a-kind piece on your wall.

Reviews
There are no reviews yet.